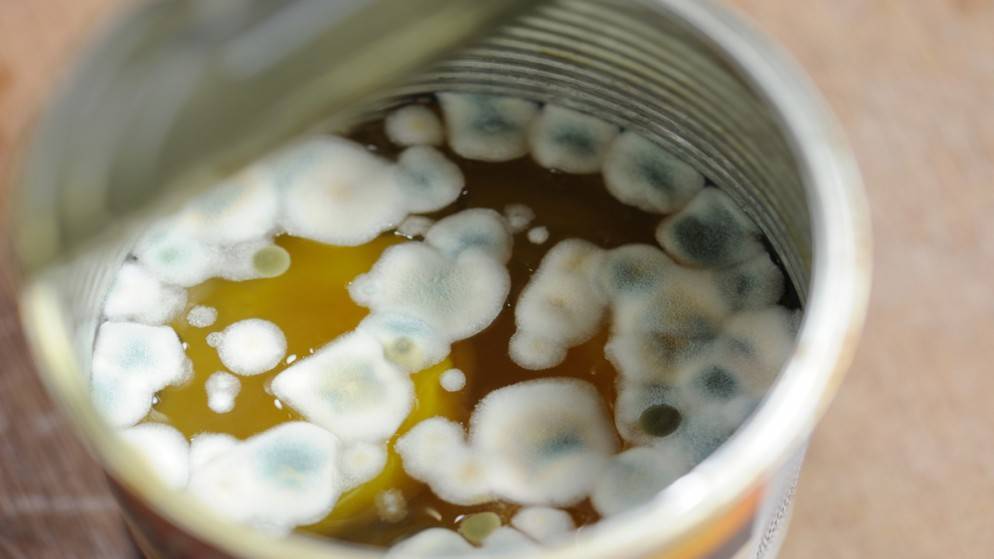

محليات
-

-

-

-

-
 الملك يهنئ بعيد استقلال تونس2024-03-19
الملك يهنئ بعيد استقلال تونس2024-03-19 -

-
 مستجدات حالة الطقس في الأردن الأربعاء2024-03-19
مستجدات حالة الطقس في الأردن الأربعاء2024-03-19 -

-

-

-

-
-

-

-

-

-

-

-
 اخماد حريق داخل مشغل دهانات وأخشاب في عمان2024-03-19
اخماد حريق داخل مشغل دهانات وأخشاب في عمان2024-03-19 -

اقرأ أيضا
-
 قرارات مجلس الوزراء2025-12-14
قرارات مجلس الوزراء2025-12-14
















